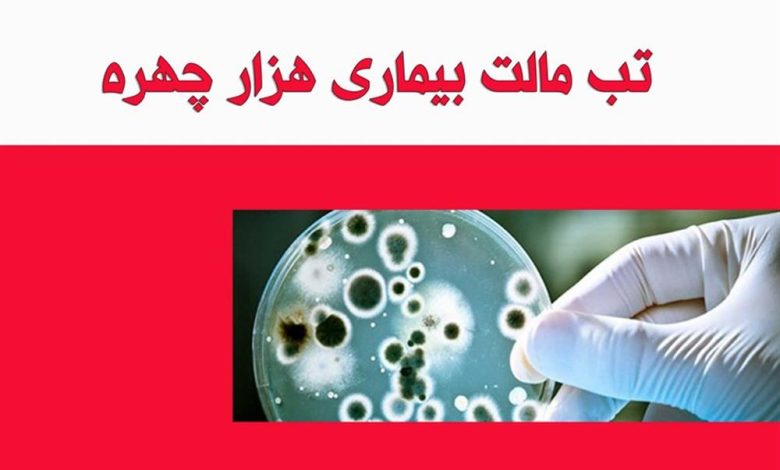

تبدیل همدان به الگویی موفق در پیشگیری از تب مالت و واکسیناسیون/ کاهش ۶۰ درصدی تب مالت
مدیر گروه پیشگیری از بیماریهای واگیر معاونت بهداشتی دانشگاه علوم پزشکی همدان گفت: در سالجاری آمار ابتلا به تب مالت در استان نسبت به سال های گذشته ۶۰ درصد کاهش یافته است.
به گزارش موج الوند، یعقوب اندامی با اشاره به اقدامات انجامشده در زمینه کنترل بیماریهای واگیر، اظهار کرد: استان همدان در حال حاضر جزو موفقترین استانهای کشور در کاهش میزان ابتلا به بیماری تب مالت به شمار میرود. این در حالی است که در سالهای گذشته، همدان یکی از استانهای با شیوع بالای این بیماری محسوب میشد.
وی با بیان اینکه این موفقیت حاصل برنامهریزی منسجم و همکاری بینبخشی است، افزود: با اجرای اقدامات هدفمند، پیگیریهای مستمر حوزه بهداشت و همکاری مؤثر با ادارهکل دامپزشکی استان همدان، خوشبختانه شاهد کاهش چشمگیر موارد ابتلا به بیماری تب مالت در سطح استان هستیم.
مدیر گروه پیشگیری از بیماریهای واگیر معاونت بهداشتی دانشگاه علوم پزشکی همدان در ادامه به نقش نظام مراقبت و پایش دقیق اشاره کرد و گفت: تمامی آزمایشگاههای خصوصی فعال در استان تحت نظارت دانشگاه علوم پزشکی همدان فعالیت میکنند و موظف هستند کوچکترین موارد مشکوک به تب مالت را بهصورت فوری گزارش دهند این روند موجب شده است استان همدان از نظر شناسایی و ثبت موارد تب مالت، یکی از استانهای دقیق و قابل اتکا در سطح کشور باشد.
وی همچنین با اشاره به وضعیت بیماریهای تنفسی در استان تصریح کرد: در حال حاضر پیک آنفولانزا در استان همدان فروکش کرده و میزان تستهای مثبت از ۳۹.۵ درصد به حدود ۵ درصد کاهش یافته است. خوشبختانه استان از وضعیت هشدار خارج شده و پیشبینی میشود با ادامه این روند، در هفته آینده میزان کل تستهای مثبت به حدود ۳ درصد برسد.
اندامی در بخش دیگری از سخنان خود، استان همدان را از استانهای موفق کشور در حوزه واکسیناسیون دانست و افزود: با توجه به پوشش بالای واکسیناسیون، استان همدان در زمره استانهای برتر کشور در این حوزه قرار دارد.
وی با اشاره به افتتاح زنجیره سرد معاونت بهداشتی دانشگاه علوم پزشکی همدان خاطرنشان کرد: با راهاندازی و تجهیز زنجیره سرد، تا سالهای آینده هیچگونه مشکلی در زمینه ذخیرهسازی واکسن در استان وجود نخواهد داشت و این زیرساخت نقش مهمی در حفظ کیفیت و اثربخشی واکسنها ایفا میکند.
مدیر گروه پیشگیری از بیماریهای واگیر در پایان به برخی چالشهای اجرایی اشاره کرد و گفت: مشکلاتی در زمینه حملونقل واکسن، از جمله کمبود خودروهای ویژه حمل و یخچالهای استاندارد نگهداری واکسن وجود دارد که پیگیری برای رفع این مسائل در دستور کار قرار دارد.





